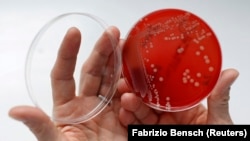
An employee at a microbiological laboratory in Berlin displays MRSA, a drug-resistant "superbug" that can cause deadly infections.

Drug-resistant “superbug” infections have been called a public health threat that could push medical progress back a century. Health experts warn such infections could cause some germs to become untreatable.
So there was surprising news in a recent report: superbug deaths in the United States appear to be going down.
About 36,000 Americans died from drug-resistant infections in 2017, compared to an estimated 44,000 in 2013. That information comes from the U.S. Centers for Disease Control and Prevention (CDC).
The recent CDC report says the decrease is mainly the result of a major effort by hospitals to control the spread of very dangerous infections.
“We are pushing back in a battle we were losing,” pharmacist Michael Kirsch told The Associated Press. He works at AdventHealth Tampa, a Florida hospital that has noted lower superbug infection rates.
“I would not, by any means, declare success,” Kirsch said.
And he’s right.
Though superbug deaths are decreasing, nonfatal infections grew nationally, from 2.6 million in 2013 to 2.8 million in 2017. Some troublesome new germs are developing. And superbugs are appearing much more often outside of hospitals, the CDC report said.
For example, urinary tract infections have been easily treated in doctor’s offices with common antibiotic medicines. But now it is more common to see young healthy women with such infections admitted to hospitals after their treatments do not work, said Doctor Bradley Frazee. He works at a hospital emergency room in California.
“We never really worried about this kind of antibiotic resistance in the past,” said Frazee. Last year, he was lead writer of a report which noted more than 1,000 drug-resistant urinary tract infections at Highland Hospital in Oakland.
Antibiotic drugs first became widely available in the United States during the 1940s. And today antibiotics are used to kill or control bacteria that cause all kinds of infections, from strep throat to the plague.
But some antibiotics have stopped working. Experts say overuse and misuse have made these drugs less effective.
The new CDC report marks only the second time the government agency has tried to measure the numbers of U.S. illnesses and deaths linked to drug-resistant germs. The first report was released six years ago. This time, the CDC used new information and re-examined the 2013 numbers. This led to larger estimates.
The 2013 report estimated that superbugs were to blame for more than 23,000 U.S. deaths and more than 2 million infections each year. Those numbers were based on 17 germs that were considered the greatest threat.
But the 2013 count did not include the thousands of deaths and illnesses from a nasty bug called Clostridium difficile. It is considered part of the larger problem because, when antibiotics kill other bacteria, C. diff can grow uncontrollably. The good news is C. diff infections and deaths have also been decreasing.
Overall, public health officials admit the superbug problem is probably even bigger. A 2018 paper suggested more than 153,000 Americans die each year from infections resulting from two or more drug resistant organisms.
The difference is in where researchers get their data and what is included.
Dr. Jason Burnham was the lead writer of the paper. He says there is not agreement worldwide on how to define a drug-resistant infection.
Burnham is an infectious diseases researcher at the Washington University in St. Louis, Missouri.
For the newly released report, CDC researchers examined new sources of records for data. For example, some earlier estimates were based on reports from about 180 hospitals. This time, CDC was able to use the electronic health records of about 700 hospitals.
Among the CDC’s other findings:
—There were fewer cases of several nasty hospital-related germs, including drug-resistant tuberculosis and the bug known as MRSA.
—Infections from the bacteria CRE – often called the “nightmare bacteria” -- stayed about the same instead of increasing.
U.S. health officials credit hospitals for using antibiotics more carefully, and doing more to isolate patients with resistant infections. They also believe government money for laboratories has helped researchers more quickly identify drug-resistant germs and take action against them.
Still, CDC officials said there’s not much cause for celebration.
“There are still way too many people dying,” said Michael Craig, a leader in CDC’s superbug threat research. “We have a long way to go before we can feel we can even get ahead of this.”
I’m Jill Robbins. And I’m Alice Bryant.
Mike Stobbe reported this story for The Associated Press. Alice Bryant adapted the story for VOA Learning English. George Grow was the editor.
_____________________________________________________________
Words in This Story
germ – n. a very small living thing that causes disease
pharmacist – n. a person whose job is to prepare and sell the drugs and medicines that a doctor prescribes for patients
nonfatal – adj. not causing death
urinary tract – n. the body’s drainage system for removing urine
illness – n. a sickness or disease
data – n. facts or information used usually to calculate, analyze, or plan something
nightmare – n. a dream that frightens a sleeping person
isolate – v. to put or keep someone or something in a place or situation that is separate from others